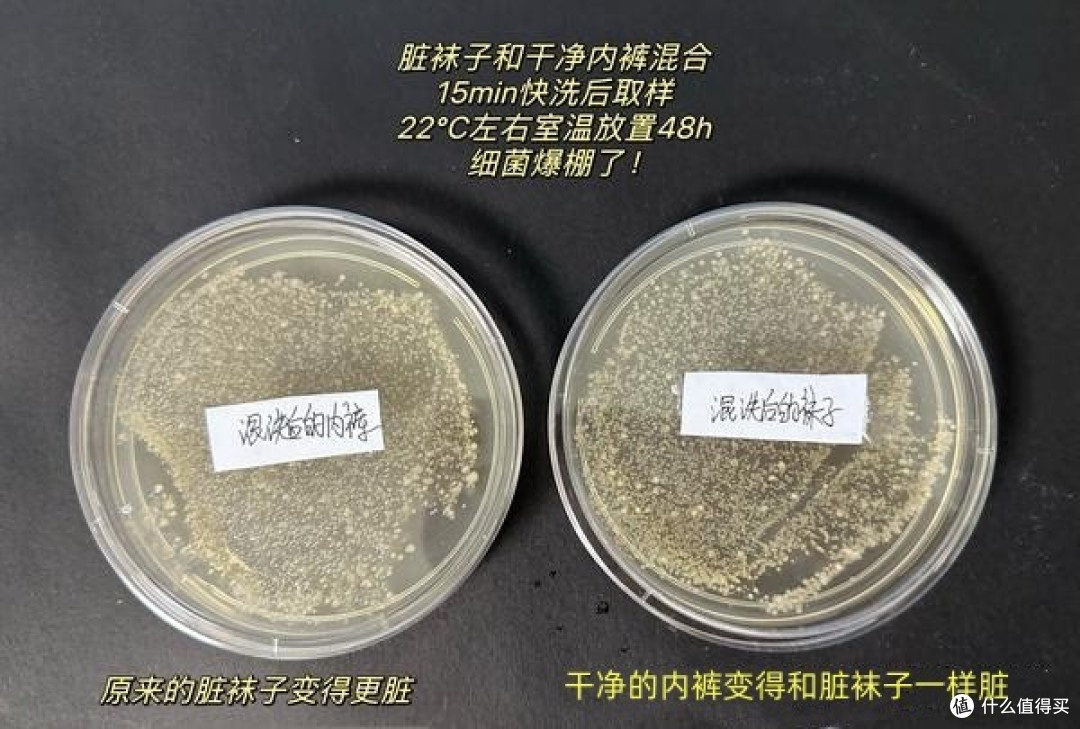
小米出了分区洗衣机，袜子分开洗，到底是伪需求还是真刚需？

小米出了分区洗衣机,用正常洗衣机的尺寸,做了大小筒分割,大桶洗正常的衣服,小筒洗内衣内裤、或小朋友的衣服,东西一上市,就火了一把。

但同时,也激起了新一轮的争议:分区洗,到底有没有必要?
两大阵营真的是各执一词....
那么本期,咱就来科学、客观的分析下,到底洗衣机的分区洗,在家用场景中,是伪需求还是真刚需?
认为「没必要」分区洗的理由:看了大家的理由,咱姑且给它分为豪放派、担忧派、现实派、科学派、举一反三派和研究派六个派别。
01 豪放派
内裤、袜子都是衣着的的一部分,不应该被嫌弃!

这方执辞的原因简单粗暴,脚还碰床单呢,那是否床单也需要分开洗?泡脚时,脚丫子和屁股还都要裸露在同一水域,你有异于常人的姿态避免吗?
既然做不到,就不应该双标,不管哪里的衣服,就应该一视同仁、一起在洗衣机里转圈圈。
02 担忧派
分区洗,筒径小,无法洗干净。

众所周知,滚筒洗衣机的清洗原理是滚动中提升、摔下,模仿棒槌击打衣物达到清洁的目的,一旦内桶缩小,就会有摔打力度减小、清洁能力随之下降的问题。
03 现实派
洗衣机内筒脏,分不分区洗都一样脏

洗衣机的内桶脏,已经是大家有目共睹的事实,只要内桶清洁的问题一天不解决,那么都会存在交叉污染的情况。
比起外在细菌侵染,自身互利共生的这些菌不足为患,所以,这时分不分区都是一样的脏,就压根没有必要分区。
04 科学派
科学派讲究:洗衣液除菌和晾晒太阳杀菌两种。

如果说前者是杜绝问题,那么后者就是巩固,除菌型洗衣液的除菌率高达99.9%,再加上太阳中紫外线的消毒辅助,两者强强结合,即便最后仍有少量细菌侥幸存活,我们还有免疫系统保护。

正常情况下,都不会对身体造成危害,所以,没有必要将小东西就能解决的问题上升到换洗衣机、分区洗的层面。
06 举一反三派
外国的公共洗衣房

在国内,公共洗衣房不是非常流行,但是在一些发达国家,路边的自助洗衣店非常多,如果混洗会致病,那么公共洗衣房的方案,是不是早都被取缔了?
事实是没有,何况咱家用洗衣机还只牵扯自家人,那何必“庸人自扰”呢?
07 研究派
内裤比袜子脏
微生物学家曾做过研究:一条内裤平均带有0.1克粪便。

在人体排泄物中,除了1/4的水分及未消化的食物残渣,还有脱落的肠上皮细胞和肠道微生物,如大肠杆菌、双歧杆菌等等。
甚至有报道说,“一克粪便中含有1000万个病毒、100万个细菌、1000个寄生虫包囊和100个虫卵。”

而袜子上却只有体表定植菌,虽然闻着酸臭,但只是出汗之后的产物被细菌分解产生的异味,即使转移到别处,也不会对皮肤造成什么影响。
所以,袜子和衣服完全可以混洗,也就是说,没有必要分开洗。
认为「有必要」分开洗的理由:说完没必要分开洗的红方,我们再来说说认为有必要分开洗的蓝方理由:
01 心里的坎迈不过去

很多人潜意识里就觉得袜子比内裤脏,内裤又紧贴隐私部位,别说混洗了,就单单脑补一下那个场景,就能浑身起鸡皮疙瘩。
心里的那道坎迈不过去,就只能分开洗,否则浑身会不自在,甚至还会产生“意念性”瘙痒。
02 脚是真菌,洗衣液、太阳杀不死
上面说了正常情况下,脚上的菌不会对皮肤造成影响,但是还有非正常情况,那就是——脚气!
脚气足藓可是真菌,据统计,脚气患者一双袜子上可能拥有超十万个真菌,关键真菌洗衣液、太阳杀不死。

一旦带着这些病原体的袜子与衣物混洗,这些真菌就有可能转移到别的衣服上,导致股癣、体癣及其它皮肤瘙痒类疾病。
不想染一身皮肤病,还是分类洗衣吧。
03 惨痛经历
因为不注意衣物分类清洗,而引发疾病的人不在少数。
北京的王女士就自述,平时自己工作比较忙,下班还要带孩子上课、辅导作业,家里又没有可以帮忙的人,自己家的衣服都是一桶混,后来得了妇科病,才知道科学洗衣应该是贴身衣物分开洗,而且医生也是这么建议的。

山西的陈先生说,自己是有轻微的脚气,但想着衣服清洗后,就不会存在交叉感染的问题,然而直到自己得了灰指甲,才知道洗完的衣服还是会有细菌残留,并且会迁移到其它部位。
类似的惨痛经历还有很多,但无一例外都是衣服混洗造成的,为了避免别人的教训发生到自己身上,衣服绝对有必要分开洗。
那到底真的有没有必要分开洗?带着这个疑问小住去翻阅了许多资料,大致的答案如下:
直接明确说可以混洗的:
大多是一些自媒体、用户评论。
科普可混洗,但加了限定条件的:
大部分的科普机构、论文,下面是一些机构的观点:
@网易浪潮工作室:袜子和内裤究竟能不能一起洗?答案是可以。
在没有杀菌条件的情况下,袜子内衣和其他衣服分开洗,反倒更安全。

但是现代化社会,有条件杀菌:
一是在洗衣过程中增加含有活性氧的漂白、消毒剂;
二是利用热水,60度以上的水温,可以消灭袜子上60%以上的真菌,热水除了杀菌,还能激发漂白剂的潜力,在52℃以下洗15分钟,袜子上的真菌就不会迁移到别的衣物上,有加热功能的洗衣机都可以实现;

三是烘干,烘干能进一步杀灭残留在衣服上的病菌,在高温和快速脱水的双重制裁下,让病菌没有喘息生存的机会。
@丁香医生:袜子和内裤能不能一起洗?要分情况。
可以混洗的情况是:

一是,一人一机,都是自己身上的菌,且每日一换内裤、袜子,就可以一起洗;
二是,免疫力正常,没有皮肤和生殖器不适时;
三是,洗完的衣服能确保迅速晒干、晾干或烘干时。
需要分开洗的情况是:

一、不清楚洗衣设备的其它使用者身体状况的;
二、自身有洁癖、生理期、肛肠疾病、足癣、皮肤脱皮、损伤、瘙痒症等特殊情况的;
三、家里有猫猫狗狗、小朋友的,前者菌落复杂,后者免疫力相对成年人较弱,还是得注意。
@庄有猫:袜子和内裤能不能一起洗?男生影响不大、女生建议分开洗。

他给了一个曾经发表在顶级期刊PNAS(美国科学院院报)上的一个文章,主要的结论除了女性的菌落会多于男性,还因为男女生理结构的差异。
包括女性尿道较短,尿道口、阴道口及肛门距离较近、阴道内有更多褶皱,这些都导致女性的生殖及泌尿系统更容易被感染,女性泌尿系统感染的概率大约是男性8-10倍。

还有就是,前几年河北对于农村妇女真菌感染的一项研究就表明,生活中将袜子和内衣同洗一组的真菌检出率(56.69%)明显高于分开清洗一组的检出率(39.44%),这也是支持女性将内衣袜子分开洗的重要证据。
另外,发表在中华流行病学杂志上的一项研究就显示,总是将洗过的内裤放在太阳下晒干的女性中,患有生殖道感染的概率(72.6%)显著低于那些不将内裤在太阳底下晒干的女性(86.3%)。对于自己或者家里有足癣、灰指甲等真菌感染者的女性来说,务必要分开洗涤。

因此,如果是男生的话,分开洗还是一起洗,影响不大;而如果是女生的话,还是建议内裤袜子分开洗,并且把衣服放在太阳底下晒干。如有必要,可以洗涤时加上衣物消毒水。
强烈建议分开洗的:
都是做过实验,检测过细菌的或者医生。
@Wiki赵,他做了两个实验:一是干净的内裤和脏袜子一起放到消毒后的洗衣机里测试;二是干净和内裤和干净的袜子一起放到长期不清洁的洗衣机里测试。
前者的结果是:和脏袜子一起洗的内裤上沾满了细菌!洗完后的袜子竟然比洗前还脏!而且脏太多、太多、太多!

后者的结果是:原本干净的内裤和袜子上都有了细菌残留,也就是说脏的洗衣机会让衣服越洗越脏。
@若干个医生,都曾语重心长的劝过大家,要分开洗,并且讲很多案例!
所以,关于是否有必要分开洗的答案是:
YES
建议选择带杀菌、烘干功能的洗衣机,或者双筒分区的洗衣机。
但,仅仅把袜子分开洗还不够看完上面的内容,估计大家心里也都有杆秤了,但是仅仅把袜子分开洗,远远不够,还需要注重:
01 洗衣机内筒清洁,也同样重要

其实除了wiki赵的第二个实验,洗干净的内裤、袜子,哪怕是放到长期不清洁的洗衣机里15分钟快洗,也会感染上细菌,日常洗衣机内桶的脏,也是有目共睹的。
既然脏,我们给它清洁就好了,新买回来的洗衣机,其实可以用筒自洁功能,频率大致是一月一次,就能将内桶洗的很干净。

但如果是长期未清洁、或者没有按频率筒自洁的洗衣机,这时再用筒自洁功能就清洗不干净了,需要洗衣机内桶清洁剂的辅助。
在这里需要注意,传统的洗衣机清洁剂其实不适配滚筒洗衣机,滚筒洗衣机因为没有全筒储水功能,需要选择免浸泡的活性清洁剂。

另外功能成分最好选择带消毒、除霉和除异味的,只有配方齐全才能由内筒、到胶圈,全部清理干净。
02 双分区不够,需要三分区
双分区只能是常规衣物和袜子,要得追求完全的干净,就不够。

家里人至少得每个人一个区,或者平常衣物、袜子、内裤分别一个区,才能彻底消除心理关卡。
03 清洁剂,也有讲究
前文说到过,日常生活中我们用的洗衣粉、洗衣液虽然能去污,但是杀菌效果很有限,要得充分杀菌,需要在洗衣的时候加入漂白剂,怕漂白剂伤害衣服的,可以选择彩漂,对衣服相对柔和一些。

另外就是,要选择带有国标的的,中国抗菌抑菌洗涤剂的行业标准(QB/T 2850-2007)规定抗菌性洗涤剂的杀菌率需要超过90%,选择带国标标准的,才能达到杀菌、抗菌目的。
04 其实手洗也合理
目前没有换洗衣机打算的,或者时间充裕的,还是建议手洗吧,毕竟这是让自己心安的最好方式。

洗完之后,最好再配合热水烫一下,彻底消除细菌。
写到最后分区洗衣机虽然不是真刚需,但也绝对不至于是伪需求,无论如何雷军都是了解用户的神,能从从用户真正的痛点出发做设计,而且还是在同样空间消耗下,给大家多了一种选择,这一点非常棒。
无论最后是否能真实解决痛点,都在朝着更好的方向发展,引领作用还是很明显的。